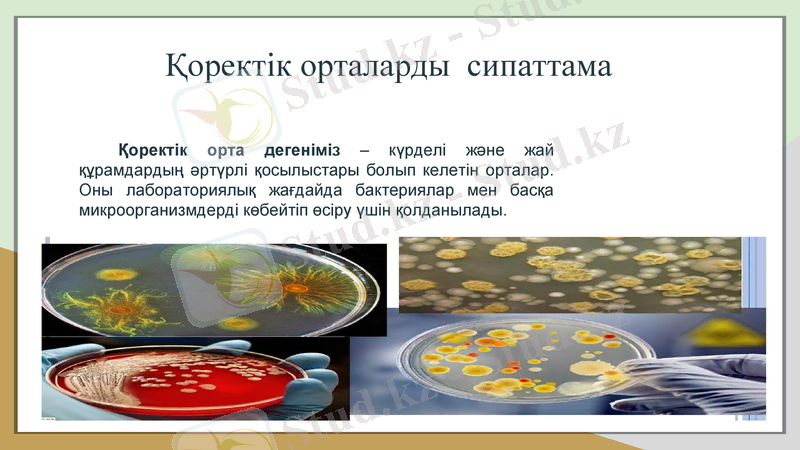
Slide 2
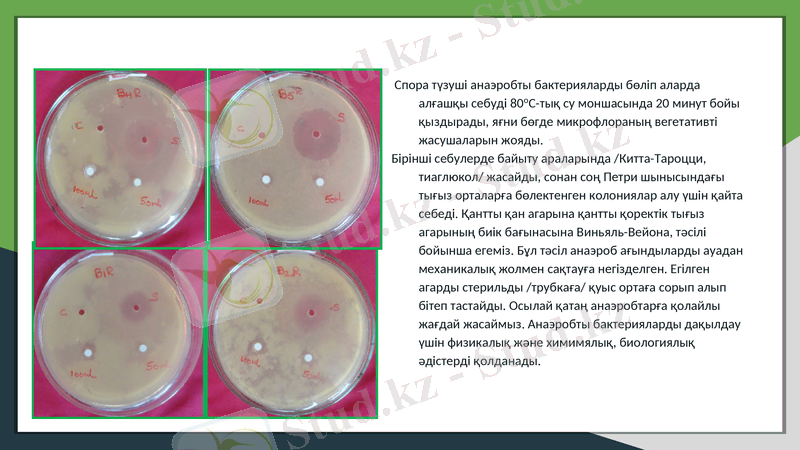
Slide 9

Қоректік орталар: дайындалуы, түрлері және микробиологиялық дақылдау әдістері



Қоректік орталарды дайындау
Дайындаған: Салиев Ж
Қабылдаған:Мұқатаев А. М
Топ:ПП-903
Қазақстан Республикасының Білім және ғылым министрлігі
«Семей қаласының Шәкәрім атындағы университеті» коммерциялық емес акционерлік қоғамы
Қоректік орталарды сипаттама
Қоректік орта дегеніміз - күрделі және жай құрамдардың әртүрлі қосылыстары болып келетін орталар. Оны лабораториялық жағдайда бактериялар мен басқа микроорганизмдерді көбейтіп өсіру үшін қолданылады.

Қоректік ортаны жануардан немесе өсімдіктен туындаған өнімдерден дайындайды. Қоректік ортада өсу факторының болуы үлкен маңызға ие. Оларды дайындау үшін экономикалық рентабельді тағамдық емес шикізат қолданылады: жарамсыз қалған қан алмастырушылар, жануар қанының гидролизаты, , қан гидролизаты, биотехнология өнімдері - жем ашытқылары, жемдік лизин, жүзім ұнтағы, ақуыз лизин. Синтетикалық орталардың құрамына химиялық таза заттар - аминқышқылдары, минералды тұздар, көмірсулар, витаминдер және өсіру факторлары кіреді. Консистенциясы бойынша қоректік орталар сұйық, жартылай сұйық, тығыз болып келеді.

Құрамы бойынша - табиғи, синтетикалық және жартылай синтетикалық. Тағайындалуы бойынша негізгі, элективті және дифференциалды - диагностикалы болып бөлінеді.

Қоректік орта мына талаптарға сай болуы тиіс: бұл жерде барлық қоректік заттар жеткілікті болуы керек, тұздар, өсу факторлары, микроорганизмнің өсуіне қажетті заттары жеңіл сіңімді түрде болуы тиіс, оптимальды ылғалдылығы, тұтқырлығы, рН-ы оптимальды, стерильді болуы тиіс, мүмкіндігінше мөлдір және изотоникалы болуы тиіс. Бөгде заттар болмауы тиіс. Әрбір қоректік ортаны құрамына қарай әртүрлі әдіспен стерилизациялайды.
Универсальді (негізгі) орталар, патогенді және патогенді емес бактериялардың барлық түрлері өсетін орта. Осы орталарға жататын: ет-пептонды сорпа (ЕПС), ет-пептонды агар (ЕПА) .
Негізгі күрделі орталар - қанды, қан сарысулы және асциттік. Осы қоректік орталарды дайындау үшін 5-10%-ті дефибринделген қан не болмаса қан сарысуы, 25%- ті асциттік сұйықтықтарды қосады. Сұйық қоректік ортаны дайындау үшін осы мөлшердегі қан сарысуын не болмаса асциттік сұйықтарды қосамыз.

Элективті /селективті/ қоректік орталар әртүрлі бөгде микрофлорасынан микроорганизмнің белгілі-бір түрін таңдамалы түрде бөліп алып жинақтау үшін тағайындалған. Элективті қоректік орталарға 1 пептон суы, рН- 8, 0 тең орта, сілтілі агар /тығыз орта/, қоректік агар рН- 7, 8; Леффлер ортасы, УТА /уызды тұзды агар/, Китта-Тароцци ортасы, Мюллер, селенит, Раппопорт т. б.
Дифференциальды - диагностикалы орталар қайсы-бір микроорганизм түрлерін олардың ферментативті және дақылдық қасиеттері бойынша шектеуге қолданады. Оның құрамына мына компоненттер кіреді: негізгі қоректік орта - бактерияның өсуін қамтамасыз етеді, белгілі бір көмір-қышқылы, түрлі-түсті индикатор. Дифференциалды-диагностикалы орталарға Гисс, Рессел, Эндо, Плоскирев, висмут-сульфат агары ортасы жатады.
Қоректік орталарды келесі әдіспен стерильдейді:
1) Жоғарғы қысымдағы бу арқылы /автоклавта/ стерильдеу.
2) Кох аппараты және автоклав арқылы ағынды бумен стерильдеу.
3) Механикалық стерильдеу /фильтрлеу/.
Орталадың стерильдігін бақылау үшін 370С-та 5 тәулікке термостатқа қоямыз. Сұйық қоректік орталар мөлдір болуы тиіс, ал тығыз қоректік орталардың беткейінде өсу белгілерінің болмауы тиіс

Бактерияларды өсіру үшін келесі дақылдау тәсілдерін қолданады:
1. Стационарлы тәсіл: қоректік орталар қалыпты сақталады. Олармен ешқандай қосымша манипуляция жүргізбейміз. Осылай сұйық қоректік орталарда дақылдау тәсілінде биомассаның шығып кетуі шамалы.
2. Тереңге аэрациялық дақылдау әдісі: осы тәсіл арқылы дақылдаған кезде арнайы құрылым реактерді қолданады. Бұл жерде қалыпты температура, оптимальды рН, керекті қоректік заттың мөлшерлі түсуі бір қалыпты болады. Олар әрдайым стерильді ауамен желденіп тұрады, орта әрдайым араласып тұру үшін араластырғыш орналастырылған. Осы ерекшеліктерге байланысты биомассаның максимальды шығуын қамтамасыз етеді.

Анаэростат микроорганизмдерді анаэробты жағдайда өсіруге тағайындалған.
Хемостат - бұл аппаратта әрдайым ерекше резервуардан жаңа қоректік орта қосылып тұрады.
Турбистаттың жұмысының принципі аппараттағы бактериальды популяциясының тығыздығын сақтап тұруға негізделген. Осы аппараттарда ортаның өзгермей сақтауының арқасында, үзіліссіз дақыл керекті фазада болып тұрады. Ол маңызды биологиялық қосылыстарының яғни биомассаның максимальды шығуы қамтамасыз етеді.
Анаэробты микрофлораны алу мақсатындағы себулер қатаң анаэробты жағдайда жасалады. Спора түзуші анаэробты бактерияларды бөліп оларды алғашқы себуді 80оС-тық су моншасында 20 минут бойы қыздырады, яғни бөгде микрофлораның вегетативті жасушаларын қояды.
Спора түзуші анаэробты бактерияларды бөліп аларда алғашқы себуді 80оС-тық су моншасында 20 минут бойы қыздырады, яғни бөгде микрофлораның вегетативті жасушаларын жояды.
Бірінші себулерде байыту араларында /Китта-Тароцци, тиаглюкол/ жасайды, сонан соң Петри шынысындағы тығыз орталарға бөлектенген колониялар алу үшін қайта себеді. Қантты қан агарына қантты қоректік тығыз агарының биік бағынасына Виньяль-Вейона, тәсілі бойынша егеміз. Бұл тәсіл анаэроб ағындыларды ауадан механикалық жолмен сақтауға негізделген. Егілген агарды стерильды /трубкаға/ қуыс ортаға сорып алып бітеп тастайды. Осылай қатаң анаэробтарға қолайлы жағдай жасаймыз. Анаэробты бактерияларды дақылдау үшін физикалық және химимялық, биологиялық әдістерді қолданады.

Физикалық әдістер:
- Іс жүргізу
- Автоматтандыру, Техника
- Алғашқы әскери дайындық
- Астрономия
- Ауыл шаруашылығы
- Банк ісі
- Бизнесті бағалау
- Биология
- Бухгалтерлік іс
- Валеология
- Ветеринария
- География
- Геология, Геофизика, Геодезия
- Дін
- Ет, сүт, шарап өнімдері
- Жалпы тарих
- Жер кадастрі, Жылжымайтын мүлік
- Журналистика
- Информатика
- Кеден ісі
- Маркетинг
- Математика, Геометрия
- Медицина
- Мемлекеттік басқару
- Менеджмент
- Мұнай, Газ
- Мұрағат ісі
- Мәдениеттану
- ОБЖ (Основы безопасности жизнедеятельности)
- Педагогика
- Полиграфия
- Психология
- Салық
- Саясаттану
- Сақтандыру
- Сертификаттау, стандарттау
- Социология, Демография
- Спорт
- Статистика
- Тілтану, Филология
- Тарихи тұлғалар
- Тау-кен ісі
- Транспорт
- Туризм
- Физика
- Философия
- Халықаралық қатынастар
- Химия
- Экология, Қоршаған ортаны қорғау
- Экономика
- Экономикалық география
- Электротехника
- Қазақстан тарихы
- Қаржы
- Құрылыс
- Құқық, Криминалистика
- Әдебиет
- Өнер, музыка
- Өнеркәсіп, Өндіріс
Қазақ тілінде жазылған рефераттар, курстық жұмыстар, дипломдық жұмыстар бойынша біздің қор #1 болып табылады.



Ақпарат
Қосымша
Email: info@stud.kz